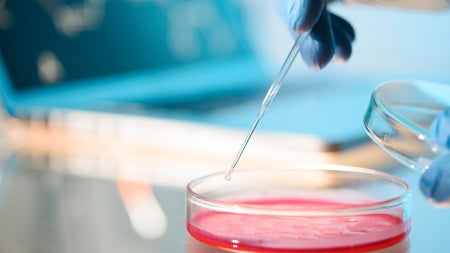
petri-dish-feat

Hear from Ramona Johnson and Sakin Kirti (2020/2021 recipients) and their mentors on their research and experiences during the year-long research project on Wednesday, October 27 from 6:15 to 7:15 p.m. CWRU will be applying for grant funding from the Beckman Foundation in the upcoming cycle. Information on program requirements will also be shared. Students should register to attend and obtain the Zoom link through Handshake.
Staff and Faculty may register to attend via Zoom registration here.